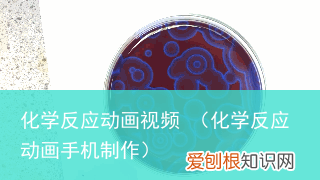
化学反应动画手机制作 化学反应动画视频

【化学反应动画手机制作 化学反应动画视频】作者:日常生活中的生物化学
1、小量浓氢氧化钾蒸发与水蒸气混和+ICl(Cr2O3)

文章插图
2、手插入氟化钾过饱和溶液

文章插图
3、信号灯瓶(浓硫酸、D-葡萄糖和轮盾石榴)
4、白血球追捕细菌

文章插图
5、铝和碘生物化学变化
6、银币+电火花
7、纸张+汽油
8、当明矾溶于热水中时,会达至饱和 。当空气冷却后,明矾就会以晶体的形式分离出来,也就是“沉淀” 。从而达至水晶一样的效果 。

文章插图
9、小双侠之环:平皿薄片上的B-Z生物化学变化(Belousov-Zhabotinsky生物化学变化)
文章插图
10、水下花园:聚丙烯的溶液中重新加入一些合金氯化钠的沉淀微粒(例如可溶、钴盐等)

文章插图
11、冰冻与镁:镁条点燃后放在冰冻当中,生物化学变化式:2Mg +CO2 → 2MgO + C,生物化学变化发出耀眼的光线 。

文章插图
12、实验室中制造的翻滚的云,可以看到在液晶上凝结的呈八边形的密集雨滴

文章插图
13、雨滴入泥土中

文章插图
14、鞭炮核爆慢放

文章插图
15、熔化汞产生硫氰化氢

文章插图
16、氟化钾瞬间积雪

文章插图
17、猪油里的氯化钠会引起墨鱼的肌肉痉挛
18、 重高氯酸铵分解

文章插图
19、合金锂熔化
20、发光的氨氧化
21、氟化钾的沉淀
22、火把重拾(冒着黑烟是固体火把小微粒蒸汽、可燃)
23、一氧化碳熔化
24、脯氨酸 - 氨和三氯乙烯、硝酸锆和溴化亚的氨
25、火柴熔化
26、 比重比水蒸气还大的铁是
27、浓硫酸重新加入对苯基
28、 常温和排球
29、 氨+氯化钠
30、 人造雪花(聚甾体钠水)
31、超冷水碰触到冰立刻凝固
32、铁棒置换氨
33、碘钟生物化学变化(跟理发没关系,变色生物化学变化有位周期,还能瘤果)
34、氮气+火
为氮气遇到火,氮气可燃易扩散,在水蒸气中可以核爆式熔化 。看看此车脱胎换骨险境的模型飞机!有木有大片即视感!
35、水+常温
这莫斯季升起的火球,当然不是核子武器核爆!只是常温与水的激烈碰触!
36、合金铯+水
小编跟你讲,这个太危险,性侵犯不要轻易去玩,成年人也表调皮,BL限制!
37、铯+氟气
把最活泼的合金铯与最活泼的非合金氟气放在一起!美不美!
38、二乙基锌+水蒸气
龙为何会喷火?其实喷的不是火,是二乙基锌!二乙基锌遇水蒸气自燃!
39、氯酸钾+糖
需要火箭原料吗?
40、三碘化氮
轻轻一碰就核爆,想想诺贝尔当年也是蛮拼的~~~
41、锶+硫磺
亮瞎了~~~
超全实验大合集
每次看见都觉得很震惊啊~
推荐阅读
- 中国湖南石门县经济排名第几
- WPS中的裁剪命令在哪里
- 古代女子闺房有什么 古代闺房的房间布局图
- 有没有好的育儿app 育儿知识哪里找
- 看到你微笑的那一秒我不安的心跳是什么歌
- 怎么跟着音乐数拍子
- 薄荷泡水喝有什么好处
- 被猫抓没破皮,被猫抓没破皮要打针吗,被猫抓没出血要打针吗,被猫抓了一下没破皮要打针吗要打针吗
- 什么是普拉提运动 ,普拉提是什么运动百度百科
